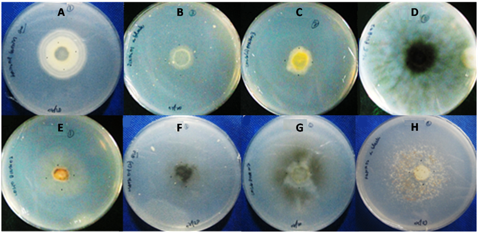
Picture8

VOLUME 10 NUMBER 2 (July to December 2017)
Philipp. Sci. Lett. 2017 10 (2) 081-088
available online: July 26, 2017
*Corresponding author
Email Address: tedelacruz@ust.edu.ph
Date Received: January 31, 2017
Date Revised: June 15, 2017
Date Accepted: July 04, 2017
ARTICLE
Butachlor biodegradation potential of fungi isolated from submerged wood and surface water collected in Taal Lake, Philippines
by Mark B. Carascal1, Marlo Jose G. del Rosario1, Kin Israel R. Notarte2,3, Fahrul Huyop4, Takashi Yaguchi5, and Thomas Edison E. dela Cruz1,3*
1Department of Biological Sciences, College of Science,
2Senior High School, and
3Fungal Biodiversity, Ecogenomics and Systematics Group, Research Center for the Natural andApplied Sciences, University of Santo Tomas, España Manila, Philippines;4Faculty of Biosciences and Medical Engineering, Universiti Teknologi Malaysia, Johor Bahru, Malaysia;
5Medical Mycology Research Center, Chiba University, Chiba, Japan
2Senior High School, and
3Fungal Biodiversity, Ecogenomics and Systematics Group, Research Center for the Natural andApplied Sciences, University of Santo Tomas, España Manila, Philippines;4Faculty of Biosciences and Medical Engineering, Universiti Teknologi Malaysia, Johor Bahru, Malaysia;
5Medical Mycology Research Center, Chiba University, Chiba, Japan
Taal Lake in the Philippines is a hotspot of diverse organisms but also faces a great threat from toxic agrochemical contaminants. Specifically, fungi are promising bioremediation agents to degrade harmful pollutants in the environment; hence the documentation and identification of these isolates are crucial. This study aims to determine the occurrence of fungi from submerged woods and surface waters in Taal Lake and assess their biodegradation potential against butachlor, a widely used pesticide in the Philippines. The isolated fungi were identified by using morphological and/or molecular methods, and the occurrence of each species was recorded. The ability of selected fungal isolates to degrade butachlor was also determined. A total of 28 morphospecies belonging to 20 fungal genera were recorded. Of these, eight fungal isolates grew on a chemically defined medium with up to 100 ppm butachlor. Two fungal isolates identified by molecular methods as Neodeightonia subglobosa IFM 63572 and Sclerotium hydrophilum IFM 63573 effectively utilized and potentially degraded butachlor as their sole carbon source as evident in the increased mycelial biomass (up to 0.449 g/L increase for N. subglobosa IFM 63572 and 0.214 g/L for S. hydrophilum IFM 63573) and decreased butachlor concentration (up to 94.68% reduction for N. subglobosa IFM 63572 and 89.64% for S. hydrophilum IFM 63573) after five days of incubation. Mycelial mat was more effective in degrading butachlor than mycelial balls. This study showed the presence of fungi from submerged woods and surface waters in Taal Lake and their potential application in the biodegradation of butachlor.
© 2026 SciEnggJ
Philippine-American Academy of Science and Engineering